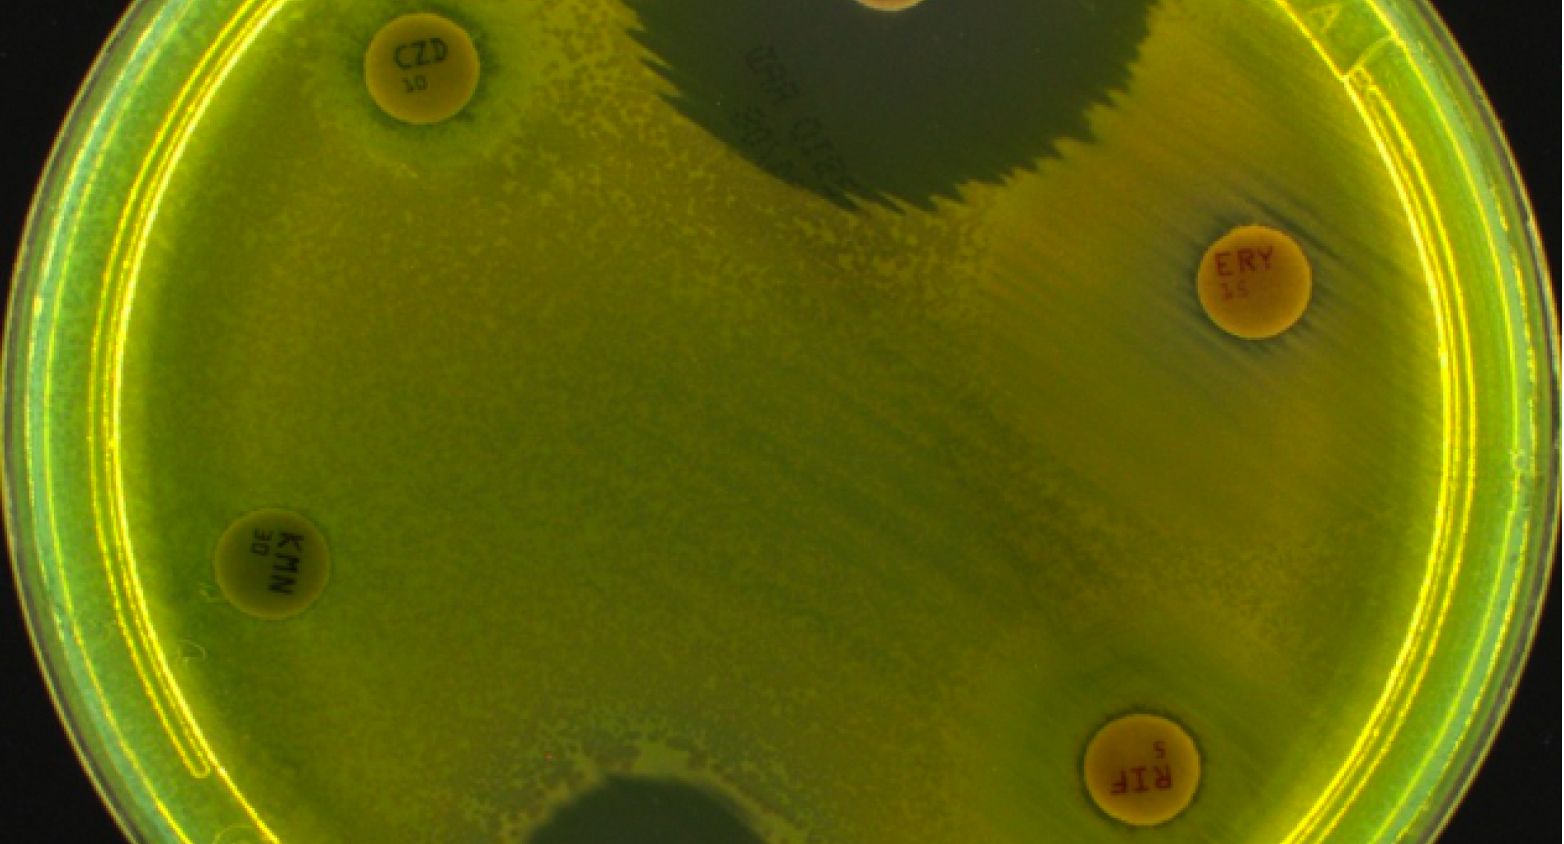
Yellow Petri dish 2
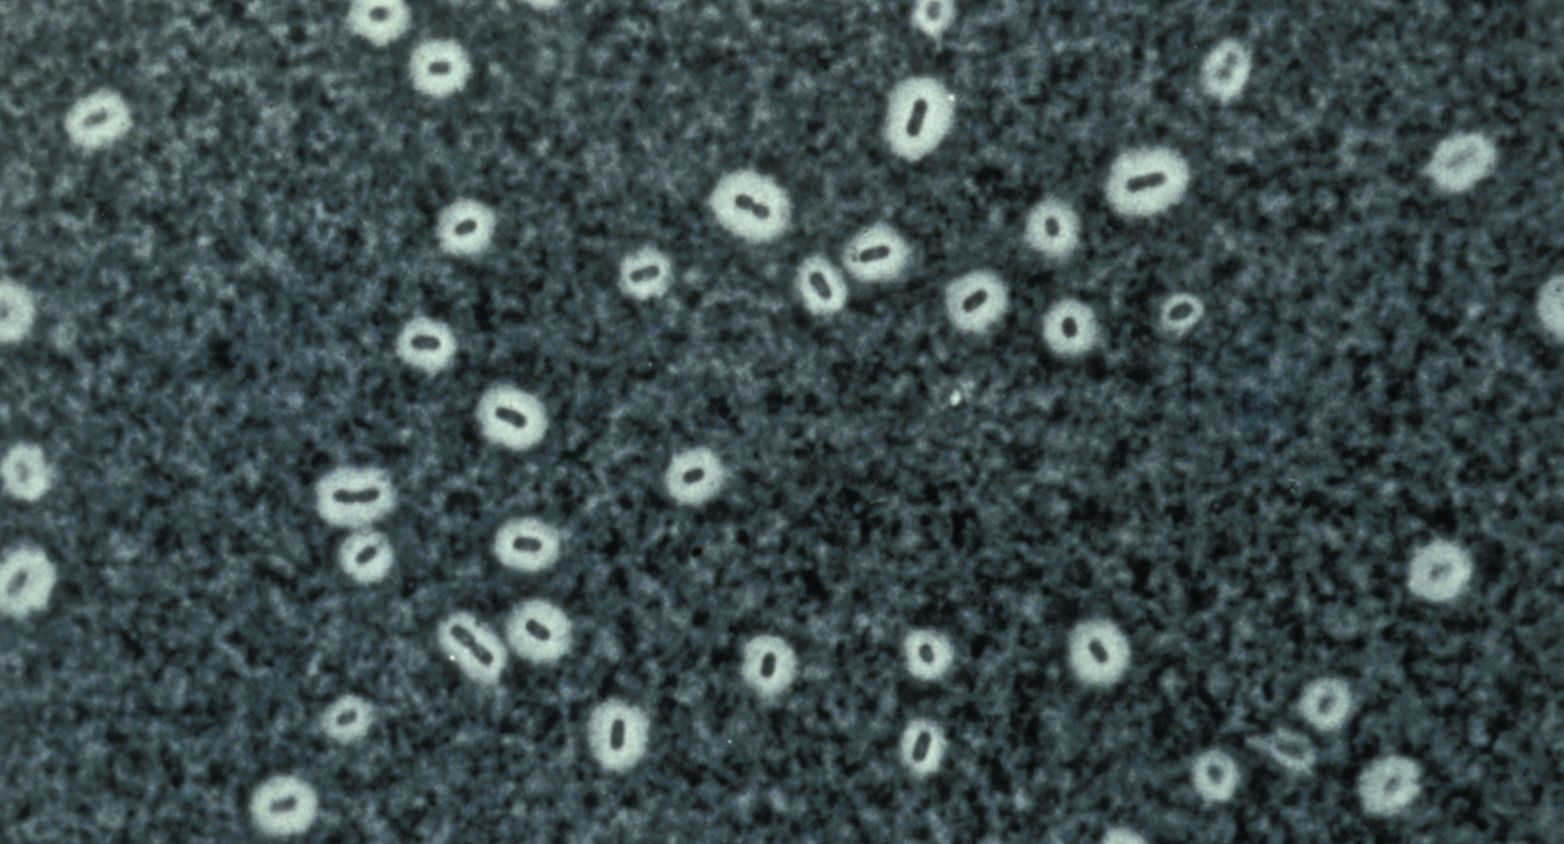
Klebsiella bacteria under microscope 2

The CIP is one of the oldest microbial biobanks worldwide. It contains more than 25 000 bacterial strains belonging to 5 500 different species. Collaborations with scientists from the Institut Pasteur and deposits of strains by French and international scientists contribute to the continuing growth of the collection. The CIP ensures the distribution of bacterial strains and associated data (data on properties, preservation conditions, identification).
Panels are proposed based on either taxonomic and/or functional caracteristics or scope of usage

World Data Centre for Microorganisms (WDCM) is a catalogue of reference strains recommended by national and international standards for quality assurance in microbiological processes, such as food and water safety, hygiene, and antibiotic control. 143 strains of the WDCM catalogue are available at CIP for distribution.
Bacterial strains for routine and extended quality controls for antimicrobial susceptibility testing (AST) by microdilution or disk diffusion, recommended by EUCAST / CA-SFM / VetCAST committees.

Clostridium perfringens is a widespread pathogen that produces different potent toxins, causing histotoxic and enterotoxic diseases. Toxinotypes in this panel are classified according to the latest toxin-based typing scheme (Rood et al., 2018).

Strains recommended for use in French educational training programs. Microbial strains are indeed needed for the education and training in microbiology of students between 12 and 18 years old.
Find out more
Escherichia coli K-12 strains for use in the identification and characterization of colicins (Pugsley, 1985). Colicins are antimicrobial proteins produced by E. coli that inhibit other E. coli strains and closely related bacteria.

Collection of 72 strains from natural populations containing most of the phylogroups of the species, and representing its genetic diversity.
Representative and type strains of each KpSC taxon to aid taxonomic or diagnostic developments.

Hospital-associated strains of various toxinotypes and resistotypes of Staphylococcus aureus.
The distribution of bacterial strains is intended for public or private research institutions and educational institutions that are equiped with laboratory facilities adapted to the handling of the requested strains.
The strains are distributed for scientific use under Material Transfer Agreement, in compliance with our internal Charter and with national and international standards and regulations.
Price list for bacterial strains
How to place an order for bacterial strains at CIP?
The CIP will reply to your request for CIP strains upon receipt of the list of requested strains and the completed “Customer account form" (french version available here). With this information, the CIP will prepare an MTA, “Material Transfer Agreement”. The MTA, with the prices for the strains including shipment fees indicated in Euro, will be sent to you to be signed by the responsible scientist and the institution in which she/he works. The order will be processed only if the MTA is properly signed.
In addition, we will also need a corresponding formal Purchase Order from your institution; please ask for it from your administrative department. Specifically for GMOs, a declaration of regulatory compliance must also be signed (french version)
Order CIP bacterial panels